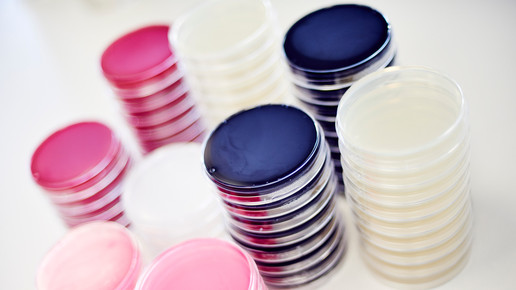

Artilysine statt Antibiotika
Immer mehr Keime sprechen auf gängige Antibiotika nicht an und führen zu Resistenzen, die für den einzelnen Betroffenen eine große Gefahr darstellen. Aber auch die öffentliche Gesundheit ist bedroht. Weltweit sind Wissenschaftler deshalb auf der Suche nach neuen Alternativen, eine Lösung könnten Artilysine der Regensburger Biotechfirma Lysando sein: Sie wirken schnell und auf physikalische Weise, ohne das Mikrobiom negativ zu beeinflussen. Geschäftsführer Markus Matuschka von Greiffenclau erklärt, warum diese Proteine die Zukunft der Antibiotika-Therapie sind.
Artilysine sind designbare Proteine, die auch persistente Bakterien gezielt abtöten. Doch „Artilysin“, eine Wortneuschöpfung aus „Arte“ für Kunst und „Lysis“ für (Auf-)Lösung, ist mehr der Name der Technologie als der einer spezifische Substanz. Das Molekül selbst besteht aus mehreren Modulen, dazu gehören Endolysin, Linker und Peptid. Diese Bestandteile sind flexibel und veränderbar. Die Proteine können so an jeden Bakterienstamm angepasst werden und liefern somit eine passgenaue Lösung. „Artilysin ist eine intelligente Technologie, mit der es gelingt, aggressive und für Mensch und Tier gefährliche Bakterien effizient auszuschalten“, sagt von Greiffenclau. Er spricht von einer „Plattform-Technologie“. Mehr als 400 Proteine haben die Wissenschaftler bisher entwickelt, darunter solche, die gegen die zwölf gefährlichsten Erreger für den Menschen wirksam sein sollen.
Das Unternehmen hat mehrere Standorte, in Liechtenstein ist das Management angesiedelt, in Bangkok und in Regensburg befinden sich die Forschungslabore. Lysando ist kein Pharma-, sondern ein Biotechnologieunternehmen. Dementsprechend werden keine präklinischen und klinischen Studien durchgeführt. Ganz im Gegenteil, die Firma nimmt Aufträge von der Pharmaindustrie entgegen, die die Artilysine zu therapeutischen Zwecken untersucht. „Auch Großkonzerne sind dabei“, erzählt von Greiffenclau. Einer der Auftraggeber sei Boehringer Ingelheim, doch mehr dürfe er nicht verraten.
Was unterscheidet Artilysine von klassischen Antibiotika? Angriffspunkt der Designer-Proteine mit lytischer Aktivität sind die Zellwände von pathogen gramnegativen und grampositive Bakterien sowie Antibiotika-resistenten Keimen. Die Eiweißmoleküle destabilisieren die Zellwand enzymatisch. In der Folge lässt der osmotische Innendruck die Bakterien innerhalb weniger Sekunden platzen – sie sterben ab. Die hohe Geschwindigkeit sei ein Vorteil gegenüber den gängigen antibiotischen Mitteln, denn die Wahrscheinlichkeit, dass sich eine Resistenz ausbilde, sei sehr gering. Hintergrund ist, dass Bakterien Zeit brauchen, um Resistenzgene auszutauschen (Konjugation); bei Artilysinen haben sie diese nicht. „Antibiotika wirken langsam, deshalb muss man sie lange einnehmen. Artilysine wirken schnell und hätten eine kürzere Einnahmedauer zur Folge“, ergänzt der 53-jährige Unternehmer.
Bakterien tragen in der Regel auf ihrer Oberfläche eine negative elektrische Ladung, Artilysine sind dagegen positiv geladen. Die elektrostatischen Wechselwirkungen werden für den antimikrobiellen Effekt ausgenutzt. Ein Effekt auf Rezeptorebene kommt nicht zu Stande, daher greift der Wirkstoff auch nicht in den Metabolismus der Bakterien ein. Neben der elektrostatische Wechselwirkung spielen für den Mechanismus auch hydrophobe sowie enzymatische Wirkungen eine Rolle. „In Kombination dieser drei Faktoren kann man die Spezifität feinsteuern“, erklärt von Greiffenclau.
Für den Wirkmechanismus sind weiterhin Eingriffe in die Endolysine sowie das Hinzufügen von Linkern und Peptiden von Bedeutung. Auch nehme die Konzentration Einfluss darauf, dass pathogene Keime spezifisch angegriffen werden. Weitere Details zur Spezifität der Artilysine und damit zum Mechanismus stellt das Unternehmen auf Nachfrage hin nicht zur Verfügung. Aufgrund der Ladung könne Artiylsin Bakterienarten unterscheiden und Krankheitserreger ausschalten, ohne die „guten“ Bakterien zu beeinflussen. Das Darmmikrobiom bleibe verschont und damit auch das Immunsystem. Ein weiterer Vorteile der Proteine ist ihre biologische Abbaubarkeit und damit Umweltfreundlichkeit.
Artilysine stellen eine neue Molekülklasse dar. „Sie sind keine Antibiotika“, stellt der Geschäftsführer klar. Die Proteine könnten bei Infektionskrankheiten, aber auch bei Wunden verschiedener Art, cystischer Fibrose und Pneumonie Anwendung finden. Aber auch Implantate könnten mit den Proteinen beschichtet werden, als präventive Maßnahme. „Der Körper wird nicht mit Antibiotika belastet. Die Bakterien können am Einsatzort keine Infektion hervorrufen.“ Laut von Greiffenclau haben Ärzte die Substanzen im Rahmen von individuellen Heilversuchen bereits erfolgreich getestet. „Voraussichtlich Ende 2019 sollte das erste Artilysin auf den Markt kommen.“

APOTHEKE ADHOC Debatte